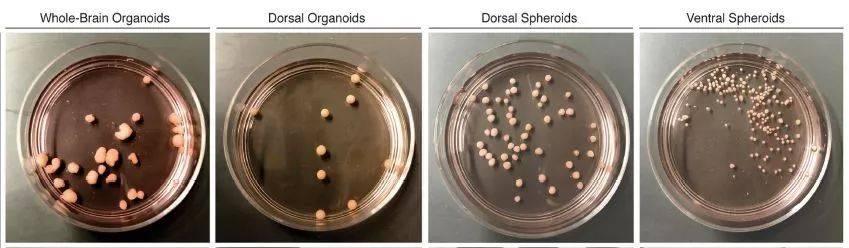

扫码打开虎嗅APP

头图来自:东方IC;本文来自微信公众号:学术经纬(ID:Global_Academia);作者:药明康德微信团队
有人说,在已知的宇宙中,人类的大脑是最复杂的东西,没有之一。
顶尖学术期刊《自然》今日上线的一篇论文中,哈佛大学和Broad研究所Stanley精神病学研究中心的科学家们带来一项技术突破,将为理解复杂的人脑和治疗神经疾病打开新的大门。

科学家们用人类干细胞在培养皿中培育出微型“大脑”,不仅如此,这些类器官可以遵循大脑皮层的发育顺序,依次产生多个类型的细胞。
类器官(organoid)是一种微型人造器官,具有3D结构,通常来源于人的单个细胞,在实验室条件下经过长时间培养,具备对应器官的一些关键特性。
利用类器官,研究者可以直接分析疾病的生物特性和机制,并用于药物筛选、器官修复材料等方面。
尽管肝脏、血管、膀胱等多种人体组织的类器官已经开始担当疾病模型。然而,大脑特有的复杂性让人脑类器官的培育在一个很重要的问题上遇到了障碍。
“我们的用脑方式或许各不相同,但每一个人拥有的脑细胞类型都一样,脑细胞的基本连接方式也是一样的。”该研究的通讯作者、干细胞和再生生物学教授Paola Arlotta解释说,“这种一致性至关重要。除了极少数的例外,每个胚胎在子宫内发育时都会重现这套一致性。就大脑内部的细胞类型和结构而言,人和人之间几乎没有差别。”

参与这项大脑类器官研究的科学家(从左到右):Joshua Levin,Xian Adiconis,Paola Arlotta,Aviv Regev,Silvia Velasco,Amanda Kedaigle和Marina Rocha(来源:哈佛大学官网;Credit:Rose Lincoln/Harvard Staff Photographer)
但是,大脑类器官要在体外培养条件下重现这种一致性却是个挑战。过去在大脑类器官培育的尝试中,虽然也能从干细胞分化产生多个类型的神经细胞,但每一次得到的细胞组合都不一样。
这种不稳定性带来的问题就是,很难用它来比较病变状态和健康脑组织的差别。
此次研究克服的就是这个难题。已故的日本干细胞生物学家笹井芳树(Yoshiki Sasai)是这一领域的先驱,最早使用胚胎干细胞培育出大脑类器官。
以他建立的方法为基础,Paola Arlotta教授与同事们对培养条件技术继续做了优化。
调整不同的分化条件后,研究团队在培养皿中分别培养出全脑类器官、背侧类前脑等四种3D组织。这些类脑器官可以在长达6个月的培养时间内健康生长。
人脑组织生长缓慢,在培养6个月后,类脑的直径达到3毫米(图片来源:Nature)
其中,模拟大脑皮层的背侧类前脑器官是研究者最为关注的。因为大脑皮层是人脑中负责认知、感觉、语言等高级功能的部分,也在很多神经和精神疾病中起着关键作用。
为了检验这些类器官的细胞类型,研究人员从培养出的21个类脑器官中分离出超过16万个细胞,用单细胞RNA测序的方法,根据在不同阶段的基因表达对细胞分组。
利用大数据分析的计算机模型,他们将类器官的细胞组成与真正胚胎大脑皮层的细胞类型进行比较。

在培养1个月的细胞团块中,可以看到不同类型的细胞,包括将成熟的神经元(图片来源:Paola Arlotta laboratory, Harvard University)
分析结果令人欣喜:95%的类器官产生的细胞类型组成几乎一致,它们遵循着相似的发育轨迹。
“产生这些类器官的干细胞来源于不同的人,所以遗传背景不尽相同。但我们发现,在每一个类器官中,都有相同的细胞类型,以相同的方式、正确的顺序产生。”研究一作Silvia Velasco博士介绍,“这样的一致性让我们非常兴奋!”

在培养6个月的大脑类器官中,不同颜色的标记结果显示出不同类型的神经细胞,体现出人脑的复杂性(图片来源:Paola Arlotta laboratory, Harvard University)
大脑类器官的这一重大进步将让研究者拥有研究大脑疾病的新方法和测试药物有效性的新工具。
据Arlotta教授介绍,他们目前正在研究自闭症,利用CRISPR/Cas9基因编辑技术开发专门与自闭症有关的大脑类器官。
“我们有了‘对照‘的类器官,就可以把与疾病有关的突变类器官与之做比较,从而确定哪些差异是有意义的,哪些细胞受到影响,哪些分子通路出了差错。这将引导我们找到疾病的特定基因特征,帮助我们采取具体的干预措施。”
“解决大脑类器官的可重复性问题在几年前还被认为是不可能做到的事,现在它为人脑研究打开了大门。”共同作者Aviv Regev教授补充说。
参考资料
[1] Silvia Velasco et al., (2019) Individual brain organoids reproducibly form cell diversity of the human cerebral cortex. Nature. Doi: 10.1038/s41586-019-1289-x
[2] Improved human brain organoids to boost neurological disease research. Retrieved Jun 6, 2019, from https://news.harvard.edu/gazette/story/2019/06/broad-institute-researchers-develop-3d-mini-brain-models/?utm_medium=Feed&utm_source=Syndication
本文来自微信公众号:学术经纬(ID:Global_Academia);作者:药明康德微信团队